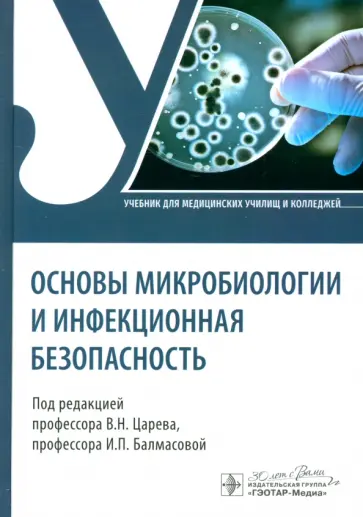
Основы микробиологии и инфекционная безопасность. Учебник Основы микробиологии и инфекционная безопасность. Учебник обложка книги

Царев Виктор Николаевич
Царев Виктор Николаевич
100
Авторы /
Царев Виктор НиколаевичЗАКРЫТЬ
Фильтры
Найдено
Сбросить
Отзывов пока нет. Поделитесь впечатлениями
Вы можете стать одним из первых, кто оставил отзыв об авторе.
Мы всегда рады честным, конструктивным рецензиям.
Написать отзыв
Внимание!
Если Вы обнаружили ошибку на персональной странице автора "Царев Виктор Николаевич", пишите об этом в сообщении об ошибке. Спасибо!
Если Вы обнаружили ошибку на персональной странице автора "Царев Виктор Николаевич", пишите об этом в сообщении об ошибке. Спасибо!
-
Позвонить -
СообщенияУ вас пока нет сообщений! -
Mой Лабиринт50 р. Дарим 50р. за регистрацию. Правила30 р. Баллы за ваши отзывы на книги5% Постоянная скидка уже на 2-й заказ -
0
ОтложеноЗдесь будут храниться ваши отложенные товары.Вы сможете собирать коллекции книг, а мы предупредим, когда отсутствующие товары снова появятся в наличии! -
0
КорзинаВаша корзина невероятно пуста.Лабиринт.Сейчас
Не знаете, что почитать?Здесь наша редакция собирает для вас лучшие книги и важные события.Главные книгиА тут читатели выбирают все самое любимое.
Ваша корзина невероятно пуста.
Не знаете, что почитать?
Лабиринт.Сейчас
Не знаете, что почитать?
Здесь наша редакция собирает для вас
лучшие книги и важные события.
Главные книги
А тут читатели выбирают все самое любимое.
- Доставка и оплата
- Сертификаты
- Рейтинги
- Новинки
- Скидки
-
+7 499 920-95-25
Круглосуточная поддержкаВсе адреса и телефоны Лабиринта
-
Круглосуточная поддержкаВсе адреса и телефоны Лабиринта
-
Круглосуточная поддержкаВсе адреса и телефоны Лабиринта
- Контакты
- Поддержка
- Главное 2026
- Все книги
- Билингвы
- Книги для детей
- Комиксы, Манга, Артбуки
- Молодежная литература
-
Нехудожественная литература
- Назад в «Книги»
- Все книги в жанре «Нехудожественная литература»
- Все книги жанра
- Бизнес. Экономика
- Государство и право. Юриспруденция
- Домашние ремесла. Рукоделие
- Домоводство
- Естественные науки
- Информационные технологии
- История. Исторические науки
- Книги для родителей
- Коллекционирование
- Красота. Этикет
- Кулинария
- Культура. Искусство
- Медицина и здоровье
- Охота. Рыбалка. Собирательство
- Психология
- Публицистика
- Развлечения. Праздники
- Растениеводство
- Ремонт. Строительство. Интерьер
- Секс. Камасутра
- Технические науки
- Туризм. Путеводители. Транспорт
- Универсальные энциклопедии
- Уход за животными
- Филологические науки
- Философские науки. Социология
- Фитнес. Спорт. Самооборона
- Эзотерика. Парапсихология
- Периодические издания
- Религия
-
Учебная, методическая литература и словари
- Назад в «Книги»
- Все книги в жанре «Учебная, методическая литература и словари»
- Все книги жанра
- Вспомогательные материалы для студентов
- Демонстрационные материалы
- Дополнительное образование для детей
- Дошкольное обучение
- Иностранные языки: грамматика и учебники
- Книги для школы
- Педагогика
- Подготовка в вуз
- Пособия для детей с ограниченными возможностями
- Словари и разговорники
- Художественная литература
- Скидки · Обзоры · Рецензии · Подборки читателей · Новинки · Рейтинг · Авторы · Изд-ва · Серии
- Все книги на иностранном языке
- Книги на английском языке
- Книги на других языках
- Книги на испанском языке
- Книги на итальянском языке
- Книги на китайском языке
-
Книги на немецком языке
- Назад в «Иностранные»
- Все книги в жанре «Книги на немецком языке»
- Все книги жанра
- Адаптированная литература на немецком языке
- Классическая литература на немецком языке
- Курсы изучения языка
- Литература на немецком языке для детей
- Нехудожественная литература на немецком языке
- Современная литература на немецком языке
-
Книги на французском языке
- Назад в «Иностранные»
- Все книги в жанре «Книги на французском языке»
- Все книги жанра
- Адаптированная литература на французском языке
- Графические романы на французском языке
- Классическая литература на французском языке
- Курсы изучения языка
- Литература на французском языке для детей
- Нехудожественная литература на французском языке
- Современная литература на французском языке
- Комиксы и манга на иностранных языках
- Все игрушки
-
Детское творчество
- Назад в «Игрушки»
- Все товары в разделе «Детское творчество»
- Все товары раздела
- Алмазные мозаики
- Витражная роспись
- Гравюры
- Другие виды творчества
- Конструирование из бумаги и другого материала
- Лепка
- Наборы для рукоделия
- Наклейки детские
- Панч-дыроколы фигурные
- Работаем с воском, гелем, мылом
- Работаем с гипсом
- Работаем с деревом
- Скрапбук
- Сопутствующие товары для детского творчества
- Творческие наборы для раскрашивания
- Фрески
-
Игры и Игрушки
- Назад в «Игрушки»
- Все товары в разделе «Игры и Игрушки»
- Все товары раздела
- Все для праздника
- Головоломки
- Детские сувениры
- Детские часы
- Другие виды игрушек
- Игрушка-антистресс
- Игрушки для самых маленьких
- Игры для активного отдыха
- Игры с мишенью
- Книжки-игрушки
- Конструкторы
- Куклы и аксессуары для кукол
- Кукольный театр
- Магнитные буквы, цифры, игры
- Машинки и Транспорт
- Мягкие игрушки
- Наборы для тематических игр
- Настольные игры
- Научные игры для детей
- Пазлы
- Роботы и трансформеры
- Ростомеры
- Сборные модели
- Слаймы
- Фигурки
- Электронные игры
- Скидки · Отзывы · Новинки · Рейтинг · Производители · Серии
- Все канцтовары
-
Аксессуары для книг
- Назад в «Канцтовары»
- Все товары в разделе «Аксессуары для книг»
- Все товары раздела
- Закладки для книг
- Глобусы
-
Обложки для документов
- Назад в «Канцтовары»
- Все товары в разделе «Обложки для документов»
- Все товары раздела
- Другие обложки
- Конверты для путешествий
- Обложки для автодокументов
- Обложки для зачетных книжек
- Обложки для паспортов
- Обложки для пенсионных удостоверений
- Обложки для проездных билетов
- Обложки для студенческих билетов
- Чехлы для карт, обложки для пропусков
- Офисная канцелярия
- Папки, скоросшиватели, разделители
-
Письменные принадлежности
- Назад в «Канцтовары»
- Все товары в разделе «Письменные принадлежности»
- Все товары раздела
- Карандаши черногрифельные
- Ручки
- Принадлежности для черчения
-
Рисование
- Назад в «Канцтовары»
- Все товары в разделе «Рисование»
- Все товары раздела
- Аксессуары для рисования
- Инструменты и материалы для каллиграфии
- Карандаши цветные
- Кисти
- Краски
- Линеры для творчества
- Мелки
- Наборы для рисования
- Палитры, стаканы-непроливайки
- Папки для чертежей и рисунков
- Пастель
- Тушь, перья
- Уголь художественный
- Фломастеры
- Холсты. Мольберты
- Сумки
-
Товары для школы
- Назад в «Канцтовары»
- Все товары в разделе «Товары для школы»
- Все товары раздела
- Веера, счетный материал, счетные палочки
- Другие виды школьной канцелярии
- Канцелярские наборы
- Косметички, кошельки
- Ластики
- Мешки для обуви
- Ножницы школьные
- Обложки для тетрадей и книг
- Папки для школьных тетрадей. Папки для труда
- Пеналы
- Пластилин
- Подставки для книг
- Рюкзаки, портфели
- Точилки
- Фартуки. Клеенки для уроков труда
- Школьная бумажно-беловая продукция
- Школьные наборы, подставки, органайзеры
- Для школы · Скидки · Отзывы · Новинки · Производители · Серии
- Все CD/DVD
-
Аудио
- Назад в «CD/DVD»
- Все товары в разделе «Аудио»
- Все товары раздела
- Аудиокниги
- Музыка
- Религия
- Видео
- Софт
- Скидки · Отзывы · Новинки · Рейтинг · Производители · Серии
- Все сувениры
- Календари
-
Сувенирная продукция
- Назад в «Сувениры»
- Все товары в разделе «Сувенирная продукция»
- Все товары раздела
- Альбомы, рамки для фотографий
- Воздушные шары
- Детские сувениры
- Значки и медали
- Конверты для денег
- Магниты
- Новогодние сувениры
- Открытки
- Пакеты подарочные
- Подарочная упаковка
- Подарочные сертификаты
- Постеры и наклейки
- Праздничные аксессуары
- Таблички и статусы для рабочего стола
- Шкатулки
- Другое
- Скидки · Отзывы · Новинки · Рейтинг · Производители · Серии
- Весь клуб
- Журнал
-
Скидки и подарки
- Назад в «Клуб»
- Акции
- Бонус за рецензию
-
Только у нас
- Назад в «Клуб»
- Главные книги
- Подарочные сертификаты
- Эксклюзивы
- Предзаказы
-
Развлечения
- Назад в «Клуб»
- Литтесты
- Конкурсы
- Дома с детьми
-
Лабиринт — всем
- Назад в «Клуб»
- Партнерство
-
Приложения Лабиринта
- Назад в «Клуб»
- Apple App Store
- Google Play
- Huawei AppGallery
Скидки и подарки
Только у нас
Развлечения
Лабиринт — всем
Приложения Лабиринта

Мы используем файлы cookie и другие средства сохранения предпочтений и анализа действий посетителей сайта. Подробнее в пользовательском соглашении. Нажмите «Принять», если даете согласие на это.
Другие способы входа
Какой сервис вы хотите использовать?
Примем заказ, ответим на все вопросы
Укажите регион, чтобы мы точнее рассчитали условия доставки
Например:
Москва,
Санкт-Петербург,
Новосибирск,
Екатеринбург,
Нижний Новгород,
Краснодар,
Челябинск,
Кемерово,
Тюмень,
Красноярск,
Казань,
Пермь,
Ростов-на-Дону,
Самара,
Омск